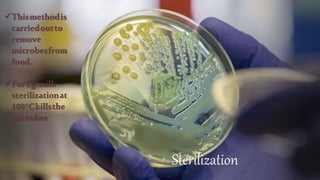
Sterilization
Thismethodis
carriedoutto
remove
microbesfrom
food.
ForEg.milk
sterilizationat
100°Ckillsthe
microbes

Food preservation aims to protect food from microbial growth and spoilage in order to extend its shelf life. There are various methods of food preservation that have advantages like increased availability and safety of foods. Common food preservation methods include use of chemicals like salt and sugar, application of heat or cold, drying, canning, irradiation, and pasteurization. Each method helps control microbes through different techniques like dehydration, high temperatures, or chemical inhibition to preserve foods for longer periods.